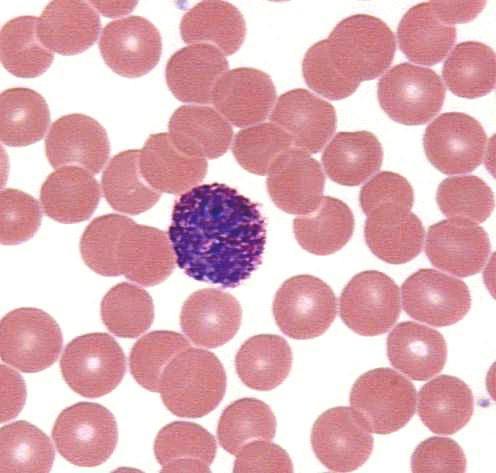

Другие названия и синонимы
Hyperchromia of erythrocytes, Гиперхромазия эритроцитов, повышение цветового показателя крови, повышение цп крови, гиперхромные эритроциты.
Описание
Гиперхромная анемия характеризуется резким снижением количества эритроцитов при одновременном увеличении содержания в них гемоглобина.
При микроскопическом изучении морфологии эритроцитов врач не только обращает внимание на размеры и форму кровяных телец, но и отмечает степень окрашивания красных клеток крови. Насыщенная окраска, закрывающая срединное просветление, которое должно быть в норме (нормохромия), в лабораторном деле носит название - гиперхромия. Гиперхромия, как правило, свидетельствует о том, что у человека развивается (или уже набрала полную силу) гиперхромная анемия. Скорее всего, она будет макроцитарной или даже мегалобластной, что в принципе, одно и то же, и что также увидит врач, разглядывая препарат (неестественно увеличенные эритроциты). И все же для окончательного уточнения диагноза понадобятся еще и другие лабораторные (и не только) методы исследования.
Гиперхромия > гиперхромная анемия.
При микроскопическом изучении морфологии эритроцитов врач не только обращает внимание на размеры и форму кровяных телец, но и отмечает степень окрашивания красных клеток крови. Насыщенная окраска, закрывающая срединное просветление, которое должно быть в норме (нормохромия), в лабораторном деле носит название - гиперхромия. Гиперхромия, как правило, свидетельствует о том, что у человека развивается (или уже набрала полную силу) гиперхромная анемия. Скорее всего, она будет макроцитарной или даже мегалобластной, что в принципе, одно и то же, и что также увидит врач, разглядывая препарат (неестественно увеличенные эритроциты). И все же для окончательного уточнения диагноза понадобятся еще и другие лабораторные (и не только) методы исследования.
Гиперхромия > гиперхромная анемия.
|
|
Нормальные значения
Норма цветного показателя и у взрослых, и у детей, исключая малышей до 3 лет, по разным источникам колеблется от 0,8 до 1,1, хотя некоторые авторы утверждают, что 0,8 это уже мало, а 1,1 уже переходит допустимые границы.
Норма ЦП у ребенка до 3 лет несколько ниже и составляет 0,75 - 0,96.
Норма ЦП у ребенка до 3 лет несколько ниже и составляет 0,75 - 0,96.

Патогенез
Гиперхромия является ведущим лабораторным признаком гиперхромных анемий и чаще всего сочетается с макроцитозом (гиперхромная макроцитарная анемия). В первую очередь в категорию подобных состояний попадают авитаминоз В12 и дефицит фолатов (фолиевой кислоты - витамина в9). Это типичные представители гиперхромных макроцитарных (мегалобластных) анемий. Почему мегалобластных. Потому что клетки значительно увеличены в размерах и представлены мегалобластами и мегалоцитами, а их диаметр (>10мкм) куда больше макроцитов (клетки с диаметром 7-8 микрон - нормоциты, больше 8 микрон - макроциты, меньше 7 мкм - микроциты), то есть, мегалобластная, значит, макроцитарная, но макроцитарная - не всегда значит мегалобластная.
Таким образом, при морфологическом исследовании образцов крови, взятых от больных с гиперхромной макроцитарной анемией, можно обнаружить:
Красные клетки крови (о них, собственно, и речь), насыщенные хромопротеином (гемоглобином) настолько, что он (Hb) стирает центральное просветление - гиперхромия (гиперхромазия);
Диаметр эритроцитов превышает 10 микрон (макроциты и мегалоциты);
Заметны фрагменты красных кровяных телец (шизоцитоз), анизоцитоз (о чем при автоматической обработке пробы свидетельствуют показатели: средний объем эритроцитов - MCV, ширина распределения по объему - RDW, гистограмма), а также изменение формы эритроцитов (пойкилоцитоз);
Нередко можно встретить красные клетки, не потерявшие ядерные субстанции (тельца Жолли, кольца Кебота, полихроматофильные элементы);
Содержание молодых форм эритроцитов - ретикулоцитов, поначалу остается в рамках нормы, однако по мере прогрессирования процесса все больше нарушается дифференцировка и их количество намечает тенденцию к снижению;
При морфологическом изучении нельзя обойти вниманием изменения со стороны белой крови: уменьшение лейкоцитов (нейтрофилов, моноцитов, эозинофилов), отсутствие базофилов, но некоторое повышение лимфоцитов. В иных случаях в кровь приходят молодые предшественники белых клеток крови - миелоциты и юные (сдвиг лейкоцитарной формулы влево);
В тромбоцитарном звене также (в умеренной степени) могут присутствовать неестественные явления (тромбоциты приобретают гигантские размеры, но общее их количество - снижено).
Всю эту ситуацию (и гиперхромию, и макроцитоз, и сдвиг лейкоцитарной формулы) создает мегалобластический тип кроветворения в костном мозге, который является общим признаком всех анемий подобного рода (связанных с нарушением образования ДНК). Анемии эти могут передаваться по наследству или приобретаться в процессе жизни.
Таким образом, при морфологическом исследовании образцов крови, взятых от больных с гиперхромной макроцитарной анемией, можно обнаружить:
Красные клетки крови (о них, собственно, и речь), насыщенные хромопротеином (гемоглобином) настолько, что он (Hb) стирает центральное просветление - гиперхромия (гиперхромазия);
Диаметр эритроцитов превышает 10 микрон (макроциты и мегалоциты);
Заметны фрагменты красных кровяных телец (шизоцитоз), анизоцитоз (о чем при автоматической обработке пробы свидетельствуют показатели: средний объем эритроцитов - MCV, ширина распределения по объему - RDW, гистограмма), а также изменение формы эритроцитов (пойкилоцитоз);
Нередко можно встретить красные клетки, не потерявшие ядерные субстанции (тельца Жолли, кольца Кебота, полихроматофильные элементы);
Содержание молодых форм эритроцитов - ретикулоцитов, поначалу остается в рамках нормы, однако по мере прогрессирования процесса все больше нарушается дифференцировка и их количество намечает тенденцию к снижению;
При морфологическом изучении нельзя обойти вниманием изменения со стороны белой крови: уменьшение лейкоцитов (нейтрофилов, моноцитов, эозинофилов), отсутствие базофилов, но некоторое повышение лимфоцитов. В иных случаях в кровь приходят молодые предшественники белых клеток крови - миелоциты и юные (сдвиг лейкоцитарной формулы влево);
В тромбоцитарном звене также (в умеренной степени) могут присутствовать неестественные явления (тромбоциты приобретают гигантские размеры, но общее их количество - снижено).
Всю эту ситуацию (и гиперхромию, и макроцитоз, и сдвиг лейкоцитарной формулы) создает мегалобластический тип кроветворения в костном мозге, который является общим признаком всех анемий подобного рода (связанных с нарушением образования ДНК). Анемии эти могут передаваться по наследству или приобретаться в процессе жизни.
Причины
• Авитаминоз В12 формируется от недостатка поступления цианокобаламина с продуктами питания, нарушения всасывания в кишечнике, конкурентного поглощения столь ценного вещества паразитирующими в организме гельминтами, нарушениях функции поджелудочной железы, в результате других заболеваний ЖКТ и воздействия токсических веществ. Какая-то часть в числе всех В12-дефицитных состояний передается по наследству;
• Что касается фолиеводефицитной анемии, то большей степени рискуют вегетарианцы, люди в возрасте, страдающие алкоголизмом люди всех возрастов, а также женщины в период беременности;
• Мегалобластная анемия с гиперхромией имеет место при нарушении активности ферментов, обеспечивающих продукцию пуриновых и пиримидиновых оснований, что нарушает синтез ДНК и РНК;
• Причиной гиперхромии (и макроцитоза) могут стать тяжелые поражения печени, влекущие значительные витаминные нарушения, ведь там (в печени) запасаются многие витамины, в том числе В12 и В9, которые являются участниками синтеза пуриновых и пиримидиновых оснований;
• Появление такого лабораторного признака в красных кровяных тельцах, как гиперхромия, не исключается при миелодиспластическом синдроме или отдельных видах гемолитических анемий, однако данный признак в подобных случаях не является стабильным показателем, все зависит от стадии процесса и его формы.
• Что касается фолиеводефицитной анемии, то большей степени рискуют вегетарианцы, люди в возрасте, страдающие алкоголизмом люди всех возрастов, а также женщины в период беременности;
• Мегалобластная анемия с гиперхромией имеет место при нарушении активности ферментов, обеспечивающих продукцию пуриновых и пиримидиновых оснований, что нарушает синтез ДНК и РНК;
• Причиной гиперхромии (и макроцитоза) могут стать тяжелые поражения печени, влекущие значительные витаминные нарушения, ведь там (в печени) запасаются многие витамины, в том числе В12 и В9, которые являются участниками синтеза пуриновых и пиримидиновых оснований;
• Появление такого лабораторного признака в красных кровяных тельцах, как гиперхромия, не исключается при миелодиспластическом синдроме или отдельных видах гемолитических анемий, однако данный признак в подобных случаях не является стабильным показателем, все зависит от стадии процесса и его формы.
Клиническая картина
Общие для всех подобных состояний симптомы (слабость, головные боли, бледность, тахикардия);
И частные - специфические (жжение языка, неуверенность походки).
При В12-дефицитной страдает кровь, желудочно-кишечный тракт и нервная система (триада синдромов), хотя для фолиеводефицитного состояния изменения со стороны нервной системы не характерны.
И частные - специфические (жжение языка, неуверенность походки).
При В12-дефицитной страдает кровь, желудочно-кишечный тракт и нервная система (триада синдромов), хотя для фолиеводефицитного состояния изменения со стороны нервной системы не характерны.
Лечение
Лечение отдельно гиперхромии, конечно, не предусмотрено. Лечат авитаминоз В12, фолиеводефицитное состояние или (что чаще бывает) - В12-фолиеводефицитную анемию.
Лечение фолиеводефицитной анемии состоит в назначении препаратов витамина В9 (витамин В9 - это и есть фолиевая кислота). Однако следует проявлять осторожность, если нет уверенности, что это именно фолиеводефицитная анемия, потому что применение в подобных случаях витамина В9 может обернуться неприятностями. Болезнь, не связанная с дефицитом фолатов, не только не отступит, а еще больше начнет проявлять себя. В этих ситуациях более оправдано назначение цианокобаламина.
Лечение самого авитаминоза В12 стоит на трех принципах:
1) Дать организму цианокобаламина вволю;
2) Постоянно, не переставая, пополнять запасы недостающего витамина;
3) Всеми силами стараться предотвратить развитие анемии, иначе потом с ней тяжело будет справиться.
Лечение фолиеводефицитной анемии состоит в назначении препаратов витамина В9 (витамин В9 - это и есть фолиевая кислота). Однако следует проявлять осторожность, если нет уверенности, что это именно фолиеводефицитная анемия, потому что применение в подобных случаях витамина В9 может обернуться неприятностями. Болезнь, не связанная с дефицитом фолатов, не только не отступит, а еще больше начнет проявлять себя. В этих ситуациях более оправдано назначение цианокобаламина.
Лечение самого авитаминоза В12 стоит на трех принципах:
1) Дать организму цианокобаламина вволю;
2) Постоянно, не переставая, пополнять запасы недостающего витамина;
3) Всеми силами стараться предотвратить развитие анемии, иначе потом с ней тяжело будет справиться.